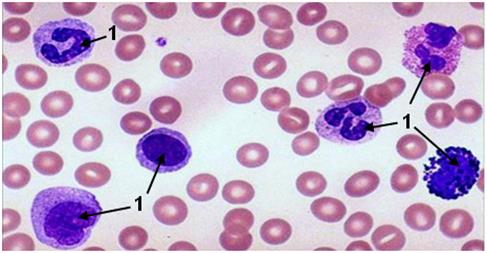

Тема. Строение ядра эукариотической клетки

Фото 35. Гладкая мышечная ткань мочевого пузыря (1- ядро). Окраска: гематоксилин-эозин.

Фото 36. Поперечно-полосатая мышечная ткань аксолотля (1 – ядро). Окраска: железный гематоксилин.

Фото 37. Клетки эпителия канальцев почки (1 – ядро). Окраска: гематоксилин-эозин.
Фото 38. Кровь (1 – ядро). Окраска по Романовскому-Гимза (эозин красный, азур II - синий).

Фото 39. Нейроны коры больших полушарий (1 – ядро). Серебрение по Кахалю.
Дата добавления: 2015-08-08; просмотров: 1949;
